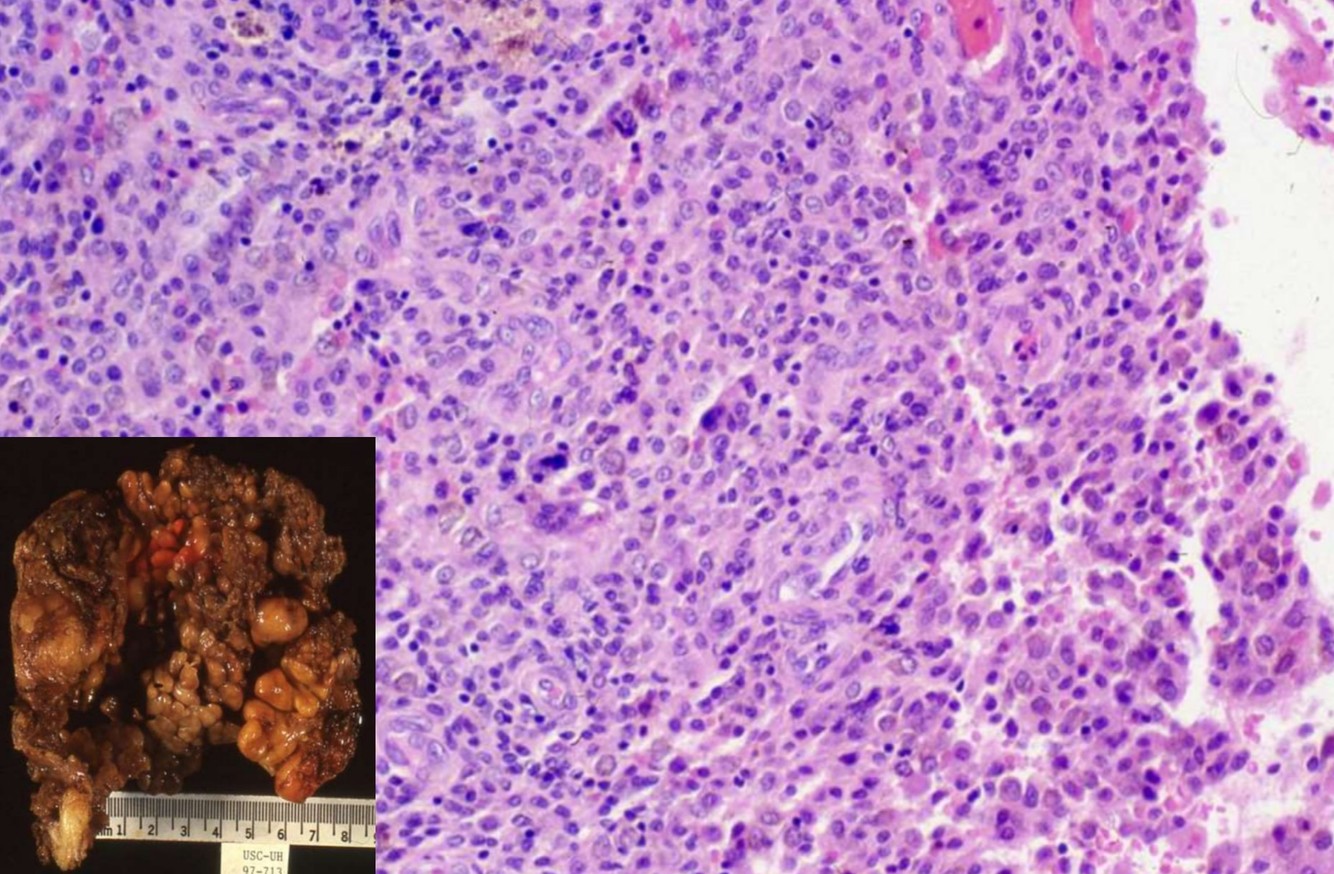

ATYPICAL FIBROXANTHOMA
- Seen primarily in the elderly population
- Predilection for sun-exposed skin, especially scalp and ear
- MFH-like tumor of the dermis
- Histology
- Well circumscribed, appears symmetric at scanning magnification
- Bizarre multinucleated tumor cells in hypercellular, spindly stroma with frequent mitotic figures, many atypical
- Also smaller fibroblastic, myofibroblastic and histiocyte-like cells with pleomorphism and angulated nuclei
- Histologically identical to MFH-pleomorphic but centered in dermis
- Background stroma appears inflammatory or reactive
- Pushes aside pilosebaceous units and eccrine glands
- Typically does not involve epidermis or subcutaneous tissue
- Lacks classic features of fibrous histiocytoma (entrapped hyalinized collagen bundles and epidermal hyperplasia)
- No grenz zone, no necrosis, no vascular invasion, no infiltrative margins
- Stains
- Positive: Vimentin, and p53
- Negative: Cytokeratin, S-100, Desmin or smooth muscle actin, LN-2 antibody (CD74)
- Diagnosis of exclusion – need to exclude the diagnosis of melanoma
- Excellent prognosis
Spindle Cell DDx Markers



PLEXIFORM FIBROUS HISTIOCYTOMA
- Primarily children and young adults; F > M
- Subcutaneous mass of the extremity
- Biphasic: fascicles of fibroblasts and plexiform nodules of histiocytoid cells with multinucleated giant cells
- Local recurrences common; distant metastasis rare

Angiomatoid fibrous histiocytoma
- t(12;16)(q13;p11)
- EWSR1-CREB1, EWSR1-ATF1, or FUS-ATF1 fusion
- children and young adults
- subcutaneous tissues of extremities
- Spindled and histiocytoid cells with cystic hemorrhages; marginated by plasma cells and lymphocytes
- Local recurrences common; distant metastasis rare

Myxofibrosarcoma
- Highly complex karyotypes, often 6p-, 9q+, 12q+
- A myxoid subtype of undifferentiated pleomorphic sarcoma
- elderly patients, predominately in extremities, 2/3 within dermis and subcutis, remainder in deep skeletal muscle or other deep tissues
- Retroperitoneal masses with similar histologic features are most likely dedifferentiated liposarcoma
- Gross:
- Superficial tumors are multiple myxoid nodules, deep tumors are a single mass with infiltrative margins
- High grade tumors often have tumor necrosis
- Histology:
- Multinodular tumor composed of pleomorphic spindle cells in myxoid background
- “Pseudolipoblasts” may be seen (tumor cells with cytoplasmic vacuoles filled with mucin/myxoid material)
- More solid areas are often seen similar to typical undifferentiated pleomorphic sarcoma
- Curvilinear vessels (thick walled with broad arc) with condensation of cells around vessels is characteristic, incomplete fibrous septa, myxoid stroma (at least 10% of tumor) and infiltrating immature dendritic cells (Am J Clin Pathol 2003;119:540)
- Has infiltrative periphery and often sends out long tentacles with frequent positive margins
- High grade tumors are more cellular with atypical mitotic figures, hemorrhage, necrosis and possibly bizarre multinucleated giant cells
- Rarely epithelioid
- Stains:
- No specific stains exists; +/- vimentin, acid mucins, CD34
- Negative: Fat stains, S100

Undifferentiated pleomorphic sarcoma
- Pleomorphic sarcoma composed of fibroblasts, myofibroblasts and histiocyte-like cells
- Diagnosis of exclusion; must sample generously and search for other components to rule out a dedifferentiated tumor or evidence of specific differentiation other than fibroblasts or myofibroblasts
- Usually older adults (age 50+ years) with slight male predominance; more common in lower extremities, rarely retroperitoneum, head and neck, breast
- Large and deep-seated with progressive enlargement
- Sarcomas adjacent to orthopedic implants or post-radiation are usually osteosarcoma or MFH
- Pleomorphic and bizarre tumor cells with foamy cytoplasm and marked atypia, in background of inflamed collagenous stroma
- Histologic types: storiform/pleomorphic, giant cell, inflammatory, myxoid
- Numerous mitotic figures, including atypical forms
- Rarely metaplastic (not neoplastic) bone or cartilage

SUPERFICIAL ANGIOMYXOMA
- Primarily young adults
- Trunk, lower extremities, head & neck
- Generally solitary, can be multiple in cases of Carney complex (endocrinopathy, mucocutaneous pigmentation, myxoma)
- Multilobulated growth, abundant stromal mucin, curvilinear vasculature, stromal,neutrophils
- Differential diagnosis: low-grade myxoid MFH
MYXOID TUMORS WITH PROMINENT VASCULATURE
MYXOID TUMORS WITH PROMINENT VASCULATURE
- Myxoid liposarcoma
- Myxofibrosarcoma
- Superficial angiomyxoma

SPINDLE CELL LIPOMA
- Subcutaneous mass, posterior neck, shoulder and upper back
- Similar tumors elsewhere classified as atypical lipomatous tumors or well differentiated liposarcoma if deep
- Men 90%, 45-65 yo
- Genetics:
- 16q or 13q abnormalities in 70%
- Frequently hypodiploid
- Gross:
- Usually 3-5 cm, well circumscribed, yellow-gray-white, firmer than classic lipoma
- Histology:
- Mature adipose tissue, spindled cells, and ropy collagen
- Floret-like multinucleated giant cells –> pleomorphic lipoma
- CD 34+

ATYPICAL LIPOMATOUS TUMOR / WELL-DIFFERENTIATED LIPOSARCOMA
- One of the most common soft tissue sarcoma of adulthood
- lower extremities and retroperitoneum
- Genetics:
- Ring or giant marker/rod chromosomes derived from 12q13-15 in almost all cases
- Amplifications of the 12q12-21 and 10p11-14 regions
- MDM2 and CDK4 by FISH or real time PCR can differentiate from other sarcomas
- Carboxypeptidase M amplification may be alternative diagnostic tool
- Other rearrangements include amplifications of 12q12-21 and 10p11-14 regions
- Histology
- Mature fat plus variably sized adipocytes and fibromyxoid stroma containing spindle cells with large, deep-staining nuclei and marked nuclear enlargement or pleomorphism
- Cellularity is low and mitotic figures are uncommon
- Usually fibrous tissue septa are present that may contain spindle cells or highly pleomorphic cells
- Some nuclei have sharply outlined vacuoles (Lochkern)
- Rarely heterologous differentiation
- No/few lipoblasts
- May be associated with metaplastic bone formation
- Rarely has low grade osteosarcomatous component
- Includes lipoma-like and sclerosing variants
- Stains:
- Postive: MDM2 and CDK4 (both together are sensitive and specific, S100 (adipocytes in 2/3 of cases), CD34 (some spindle cells), Usually p16
- Negative: HMB45

MYXOID LIPOSARCOMA/ROUND CELL
- t(12;16) translocation
- Histologic triad: abundant stromal mucin, delicate plexiform vasculature, lipoblastic differentiation
- Myxoid and round cell liposarcomas represent opposite ends of spectrum

Infant

LIPOBLASTOMA
- Genetics:
- Rearrangement of 8q11 approximately q13 region in 82%, includes PLAG1 gene
- Produces HAS2-PLAG1 and COL1A2-PLAG1 hybrid genes
- Also polysomy chromosome 8
- t(3;8)(p13;q21.1) also described
- Infants and young, M > F
- Extremities > trunk, head and neck
- Painless superficial soft tissue mass, 75% on left side
- Histology:
- Almost always subcutaneous
- Multilobular growth pattern
- Admixture of immature cells, stromal mucin and plexiform vessels

GIANT CELL TUMOR OF TENDON SHEATH
- Primarily adults
- Predilection for hands and wrists
- Circumscribed, often with fibrous bands
- Polymorphous population of histiocytoid cells, multinucleated giant cells, chronic inflammatory cells
PIGMENTED VILLONODULAR TENOSYNOVITIS
- Intra-articular counterpart of giant cell tumor of tendon sheath
- Predilection for large joints, including hip and knee
- More diffuse growth; often large amount of hemosiderin deposition
- Differential diagnosis: hyperplastic synovitis, particularly in hemophiliacs

SYNOVIAL SARCOMA
- Genetics:
- t(X;18)(p11.2; q11): SYT-SSX1 genes in 90%; can detect via PCR
- t(X;18)(p11.21;q11): SYT-SSX2 fusion genes; variants can be detected by optimizing RT-PC
- p16INK4A gene deletion in 74%
- High expression of EZH2 helps to distinguish poorly differentiated synovial sarcoma from monophasic and biphasic subtypes
- Clinical:
- deep seated mass present for years around large joints (80% in knee and ankle) in young adults (age 20-40), M > F
- 10-15% metastasize to lung and pleura, bone, regional nodes
- Minute (< 1 cm) tumors of hands and feet, F > M, median 29 yo
- Gross:
- Well circumscribed, firm, gray-pink
- Focal calcifications on Xray
- Histology:
- Biphasic, monophasic or undifferentiated
- Biphasic have spindle cells resembling synoviocytes and plump epithelial cells forming glands/cords
- Monophasic lack the epithelial cells
- Spindle cells are arranged in plump fascicles with hyalinization and distinct lobulation accompanied by mast cells, occasional osseous or cartilaginous metaplasia, focal whorling
- +/- hemangiopericytomatous vascular pattern
- Monophasic much more common than biphasic.
- Biphasic, monophasic or undifferentiated
- Stains
- Positive: Keratin, EMA, S100, bcl2, TLE1, CD99, vimentin, CEA, CD57, E-cadherin (50%), S100 (30-40%), c-kit , nuclear beta-catenin
- Negative: CD34, desmin, myogenin, h-caldesmon, CD141, WT1, FLI-1
- Mucin - spindle cell areas, PAS positive - epithelium, reticulin highlights biphasic pattern
- Poor prognostic factors: high histologic grade (based on MIB1 index and necrosis), SYT-SSX1 vs. SYT-SSX2 gene fusion

HPC-LIKE VASCULARnPATTERN
HPC-LIKE VASCULARnPATTERN
- HPC/SFT
- Synovial sarcoma
- Mesenchymal chondrosarcom

NEUROFIBROMA
- Monophasic growth; variable amount of collagen and stromal mucin
- Rare mitotic activity; presence of mitoses an ominous sign of malignancy
- Malignant transformation not uncommon, particularly in neurofibromatosis
- Plexiform NF – virtually pathognomonic for neurofibromatosis

DIFFUSE NEUROFIBROMA
- Children and young adults
- Dermal-based, but can involve subcutaneous tissues.
- Not uncommon to see hybrids of plexiform and diffuse neurofibroma; associated with neurofibromatosis in 10% of cases.
- S100+

NERVE SHEATH MYXOMA
- Controversial regarding histogenesis and classification; relationship to neurothekeoma?
- Peak incidence 4th decade
- Primarily extremities, particularly fingers
- Primarily dermis, subcutaneous tissue
- Multilobular growth
- S100+

MALIGNANT PERIPHERAL NERVE SHEATH TUMOR
- S100 negative except for epithelioid MPNST.
- Definitive diagnosis of MPNST: history of neurofibromatosis, origin from major nerve trunk, areas of a benign PNST
- Variants of MPNST: Triton tumor, MPNST with angiosarcoma, epithelioid MPNST

EXTRASKELETAL MYXOID CHONDROSARCOMA
- Deep soft tissues of extremities
- t(9;22) translocation
- Multinodular growth pattern, abundant stromal mucin
- Linear cords of eosinophilic cells, sometimes rhabdoid in appearance
- Variably S100+, keratin -, EMA -

INTRAMUSCULAR MYXOMA
- Reactive process, not a true neoplasm
- Large muscle groups of extremities, most often the thigh
- Usually solitary, sometimes multiple
- Mazabraud syndrome: multiple intramuscular myxomas and fibrous dysplasia of bone

ALVEOLAR SOFT PART SARCOMA
- Genetics:
- t(X;17)
- Chromosomen1, 5, 13, 17 abnormalitys
- Clinical:
- Deep soft tissue of oral cavity, pharynx, mediastinum, thigh/leg
- Usually young females
- Highly malignant, although clinical course is slow/indolent
- Metastases up to 30 years later to veins, lungs, other
- Lung metastases may be presenting feature
- Gross:
- Well circumscribed, large, gray-yellow, hemorrhage, necrosis
- 2-14 cm
- Histology:
- Well defined nests of cells separated by fibrous stroma
- Alveolar pattern if cells discohesive
- Composed of large polygonal cells with granular eosinophilic cytoplasm, vesicular nuclei, prominent nucleoli
- Vascular invasion common; also characteristic rod-shaped crystalloids
- No/rare mitotic figures, minimal pleomorphism
- Positive: TFE3, PAS+ diastase resistant needle-like structures, MyoD1 (cytoplasmic only)
- Prognostic impact:
- Size, presence of 17q25 abnormality, AJCC stage, age
- Diff DX: metastatic renal cell ca, paraganglioma

EPITHELIOID SARCOMA
- Adolescents and young adults
- Predilection for fingers, hands and forearm; presents as non-healing ulcers of skin
- Multiple nodules of epithelioid cells with minimal cytologic atypia, often with central necrosis
- Tumors at proximal sites such as trunk often have carcinoma-like features, including rhabdoid-like
- IHC: Immunoreactive for keratin, EMA, CD34
- Loss of INI1 expression (INI1 gene on 22q11.2)
- Differential diagnosis: carcinoma, epithelioid angiosarcoma



















